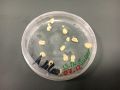

No edit summary |
|||
| Line 56: | Line 56: | ||
File:Bio (26).JPG|13.11.2018 | File:Bio (26).JPG|13.11.2018 | ||
</gallery> | </gallery> | ||
===='''''The fifth week, 20.11.2018'''''==== | ===='''''The fifth week, 20.11.2018'''''==== | ||
*Medium: | *Medium: | ||
| Line 70: | Line 71: | ||
File:Bio (33).JPG|20.11.2018 | File:Bio (33).JPG|20.11.2018 | ||
</gallery> | </gallery> | ||
===='''''The sixth week, 27.11.2018'''''==== | ===='''''The sixth week, 27.11.2018'''''==== | ||
| Line 77: | Line 79: | ||
File:Bio (36).JPG|27.11.2018, After two weeks | File:Bio (36).JPG|27.11.2018, After two weeks | ||
<gallery> | <gallery> | ||
===='''''The seventh week, 04.12.2018'''''==== | ===='''''The seventh week, 04.12.2018'''''==== | ||
====''Gallery''==== | ====''Gallery''==== | ||
| Line 96: | Line 98: | ||
File:Bio (107).JPG|07.12.2018 | File:Bio (107).JPG|07.12.2018 | ||
</gallery> | </gallery> | ||
===='''''The eighth week, 11.12.2018'''''==== | ===='''''The eighth week, 11.12.2018'''''==== | ||
====''Gallery''==== | ====''Gallery''==== | ||
Revision as of 19:34, 1 January 2019
Documentation
Physarum Polycephalum Literature
- Wikipedia link: https://es.wikipedia.org/wiki/Physarum_polycephalum
Physarum polycephalum, also referred as slime molds, belongs to the supergroup Amoebozoa, phylum Mycetozoa, and class Myxogastria. P. polycephalum, often referred to as the “many-headed slime,” is a slime mold that inhabits shady, cool, moist areas, such as decaying leaves and logs. It is sensitive to light; in particular, light can repel the slime mold and be a factor in triggering spore growth.
The first week, 23.10.2018
- Medium:
- 100ml of distilled water
- 2g of agar
- oat flakes
- After two days:
The second week, 30.10.2018
- Medium:
- 100ml of distilled water
- 2g of agar
- oat flakes
- After seven days:
The forth week, 13.11.2018
- Medium:
- 100ml of distilled water
- 2g of agar
- oat flakes
- After four weeks
I made a new sample with a new medium. Parallel to the samples that I use for the experiment I started to use this new Medium to grow the specimen
- Medium:
- 100ml of distilled water
- 1g of agar
- oat flakes
- first Day
The fifth week, 20.11.2018
- Medium:
- 100ml of distilled water
- 1g of agar
- oat flakes
- After one Week
The sixth week, 27.11.2018
- ===='''''The seventh week, 04.12.2018'''''====
- ====''Gallery''====
The eighth week, 11.12.2018
Gallery
The ninth week, 18.12.2018
Gallery
The tenth week, 25.12.2018
Gallery